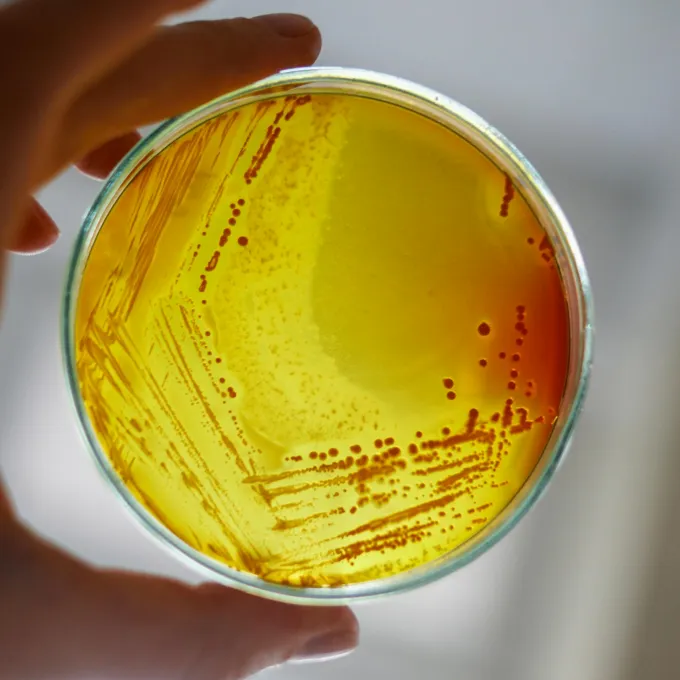
"a petri dish being held by a human"

The Human-Wildlife Interface: Disease Dynamics and Pandemic Prevention
The spread of new infectious diseases, climate change, and biodiversity loss are three of the most urgent problems facing society today, and they are intricately connected. Exploiting the environment for resources contributes to climate change and biodiversity loss, fueling increases in emerging infectious diseases. Many infectious diseases that now threaten humans originated among wildlife, yet we know relatively little about wildlife transmission dynamics and ways to prevent spillover events.
Identifying novel viral pathogens and understanding their transmission dynamics requires advanced genetic sequencing technologies, access to samples from species likely to harbor pathogens of concern to humans, and sophisticated modeling techniques. Our work focuses on one site in Uganda, though our innovative framework will inform similar projects wherever humans and wildlife are in close contact.
The Human-Wildlife Interface team will:
- apply community-driven methods that meaningfully involve residents in the research and implementation of strategies to reduce zoonotic disease transmission;
- generate data on known and novel pathogens to reconstruct viral transmission dynamics in wild nonhuman primates and neighboring human communities; and
- design and deploy new statistical tools to identify ecosystem-level scenarios likely to promote the spread of infectious diseases within and between species.
Based on our results, we will use a data-driven and community-centered approach to implement strategies to reduce the opportunities for spillover events, ultimately striving to predict and prevent future pandemics.
Faculty Leads: Krista Milich, Michael Landis, and David Wang